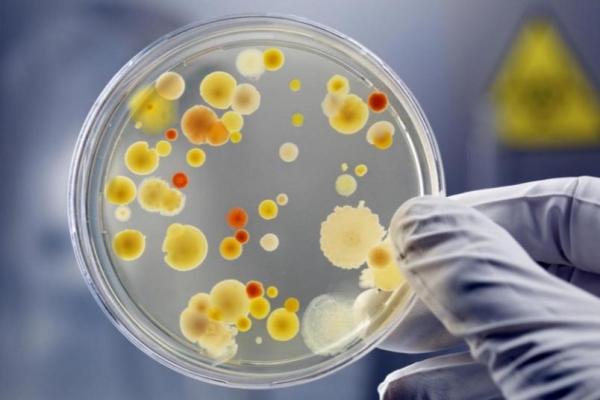

你可能想不到,春天餐桌上的"香椿头",居然跟肠道菌群扯上了关系。

更让人惊掉下巴的是,有研究声称:"香椿在短短40小时内清除体内50%的有害菌群"?真的假的?香椿真有这么神?还是又一波"养生热潮"在悄悄发酵?
我们慢慢掰开揉碎,说点实在的。
香椿是"神菜"还是"神话"?

说起香椿,很多人第一反应就是:香!尤其是春天一来,很多人恨不得天天吃香椿拌豆腐、香椿炒鸡蛋,甚至香椿腌菜都能成抢手货。
而近年来,围绕"香椿抗菌、护肠、抗癌"的传言也越来越多,尤其是那句"清除体内50%有害菌群"的说法,更是让不少人下馆子都要点一盘。
那么问题来了,香椿真的有"清菌"奇效吗?是不是吃香椿就能把肠道梳理干净,从此肠胃通畅、百病不侵?作为一名医生,我只能说:这锅,香椿它不敢背。

数据从哪来的?真相并不简单
这个所谓"40小时清除50%有害菌"的说法,出自一项细菌实验模型研究。
研究中,科学家提取了香椿中的某些成分,比如香椿素、挥发油、黄酮类化合物,并将其应用于体外的细菌培养环境中。
结果发现,这些成分对某些致病菌,比如大肠杆菌、金黄色葡萄球菌等,确实展现出一定的抑制作用,某些菌群数量在48小时内减少了约50%。

但注意,这种效果主要发生在实验室体外培养环境中,也就是在"培养皿"里,不是人体肠道。人体肠道菌群的复杂程度,远远不是培养皿能模拟的。
更何况,所谓"清除50%有害菌",这个说法本身就存在逻辑漏洞--肠道里的"好菌"和"坏菌"并非泾渭分明,很多菌种在不同环境下角色是会转化的。比如梭状芽孢杆菌,在某些情况下是有害的,但也有研究认为它在维持肠道免疫中有一定作用。
所以说,香椿可能富含一些具有抗菌活性的植物成分,但要说它"清除体内50%的有害菌",那是不靠谱的。

那香椿到底有没有用?
咱们也不能一棍子打死香椿。作为一种传统食材,香椿确实不是"花架子"。它的嫩芽中富含黄酮类物质、单宁、有机酸及挥发油等,这些成分在一些研究中表现出一定的抗氧化、抗炎作用。
有报道指出,香椿中的黄酮类物质可能对自由基的清除有积极作用,这在预防某些慢性病方面是有一定价值的。

香椿还含有丰富的膳食纤维,这对促进肠道蠕动、改善便秘是有帮助的。换句话说,它确实是一个比较"肠道友好"的食物。
那它能不能替代药物呢?答案当然是不能。香椿再香,它也不是药。对肠道菌群失调、肠炎、幽门螺杆菌感染等疾病,还是得靠正规的医学手段诊断和治疗。
有香椿吃坏肚子的?有!

说个身边的事儿:我有位朋友,平常肠胃就不算太好。
春天一到,看到市场上新鲜香椿上市,兴冲冲买了一大把。中午炒了一盘,晚上拌了一碗,第二天早上又煮粥吃。结果不到两天,拉肚子拉到脱水,连跑医院挂了两瓶盐水。
初步判断是香椿中的硝酸盐和亚硝酸盐含量偏高,加上保存不当,可能发生了部分氧化,吃进去之后刺激了肠道,引发急性胃肠炎。

这就提醒大家,香椿虽好,但也要适量。特别是春季刚上市的时候,香椿的亚硝酸盐含量较高,如果不焯水直接吃,确实可能引起不适。
香椿≠消毒水,别被养生谣言带偏
我们常说"病从口入",但"养生也可能从口入坑"。现在网络上很多所谓"神食材"的传言,其实都是夸大、断章取义,甚至就是编的。像"香椿消灭50%有害菌"这种说法,看似科学,其实没有临床依据。

肠道菌群是一个动态平衡的生态系统,一味追求"清菌",反而容易把好菌也清了,打破平衡,适得其反。临床上,我们更强调的是:增加有益菌的比例,促进菌群多样性,而不是"清除"。
与其盲目相信"吃香椿能清肠",不如日常中注意以下几点:
饭菜要清淡,油腻刺激少吃
多吃富含膳食纤维的蔬菜和粗粮
适当补充益生菌(如酸奶、发酵豆制品)
保持充足睡眠和规律作息

这些看起来没有"香椿神话"那么惊艳,但却是我们在门诊中最常给出的靠谱建议。
真要调理肠道,靠吃还不够
很多人一听说"菌群失调",就拼命吃酸奶、喝益生菌饮料,甚至天天吃"某某益生菌胶囊"。但我们得提醒一句,菌群的调节是个长期的系统工程,不是吃几顿香椿、喝几瓶酸奶就能解决的。
从医生角度看,我们在处理患者肠道菌群紊乱的情况时,往往会结合多方面手段:

饮食调整是基础
适当运动能促进肠道蠕动
有需要时使用抗生素或益生菌药物
必要时通过肠道菌群检测,进行个性化干预
光靠一种食物"翻盘",那是神话里的事。现实里,健康之路没有捷径。
香椿还能不能吃?
当然能吃!香椿本就是咱老百姓的传统时令菜,营养丰富,味道独特,适量食用对身体是有益的。只是要注意几个细节:

新鲜香椿建议焯水后再吃,可去除部分亚硝酸盐
不宜大量长期食用,尤其是儿童、孕妇、肠胃功能较弱者
香椿腌制品不宜当主菜吃,偶尔尝尝可以,但长期吃有害健康
一句话:香椿不是药也不是毒,吃对了是宝,吃错了是祸。
到底什么才是"好菌"?
这也是门诊里经常被问的问题。"好菌"和"坏菌"并没有统一标准。我们更习惯用"有益菌""条件致病菌""中性菌"等分类。
乳酸菌、双歧杆菌、酪酸梭菌等通常被认为是有益的,它们有助于维持肠道屏障、合成维生素、抑制有害菌生长。而某些大肠杆菌、产气荚膜梭菌则可能在免疫低下时引发感染。
别迷信哪种食物能"杀菌"或"清菌",更重要的是整体生活方式的调整,长期维持肠道内的微生态平衡。
你觉得香椿真能"清菌"吗?或者你有什么关于肠道健康的小妙招?